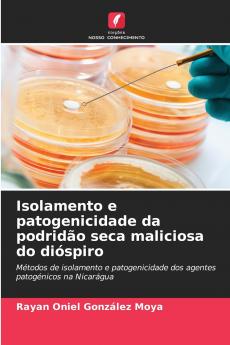
Isolamento e patogenicidade da podridão seca maliciosa do dióspiro
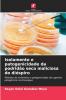
Isolamento e patogenicidade da podridão seca maliciosa do dióspiro

Portuguese
Paperback
₹5161
₹7127
27.59% OFF
(All inclusive*)
Delivery Options
Please enter pincode to check delivery time.
*COD & Shipping Charges may apply on certain items.
Review final details at checkout.
Looking to place a bulk order? SUBMIT DETAILS
Delivery Options
Please enter pincode to check delivery time.
*COD & Shipping Charges may apply on certain items.
Review final details at checkout.
About The Book
Description
Author
O quequisque é um tipo de planta herbácea de produção anual cuja alimentação contém uma forte concentração de hidratos de carbono e é uma cultura de grande importância económica para os produtores nicaraguenses que se dedicam a esta cultura principalmente em pequenas áreas localizadas sobretudo na Região Autónoma da Costa Sul das Caraíbas da Nicarágua (RACCS) No entanto esta cultura tem sido fortemente afetada pela doença do mal seco que se propaga principalmente pelo movimento do solo e de material vegetal contaminado pelo agente patogénico que até agora foi identificado como Pythium myriotylum . A metodologia normalmente utilizada na Nicarágua para o isolamento de P. myriotylum é muito laboriosa o que leva à procura de métodos mais práticos e de meios de cultura selectivos para obter culturas puras.
Details
ISBN 13
9786208763831
Publication Date
-20-03-2025
Pages
-60
Weight
-95 grams
Dimensions
-152x229x3.65 mm